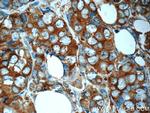
RPS25 Antibody in Immunohistochemistry (Paraffin) (IHC (P))

Search
Proteintech
RPS25 Polyclonal Antibody
{{$productOrderCtrl.translations['antibody.pdp.commerceCard.promotion.promotions']}}
{{$productOrderCtrl.translations['antibody.pdp.commerceCard.promotion.viewpromo']}}
{{$productOrderCtrl.translations['antibody.pdp.commerceCard.promotion.promocode']}}: {{promo.promoCode}} {{promo.promoTitle}} {{promo.promoDescription}}. {{$productOrderCtrl.translations['antibody.pdp.commerceCard.promotion.learnmore']}}
产品信息
23599-1-AP
种属反应
已发表种属
宿主/亚型
分类
类型
抗原
偶联物
形式
浓度
规格
纯化类型
保存液
内含物
保存条件
运输条件
产品详细信息
23599-1-AP is a rabbit polyclonal antibody raised against full-length RPS25, and is recommended for ELISA, Western blotting and IP assays.
Immunogen sequence: MPPKDDKKK KDAGKSAKKD KDPVNKSGGK AKKKKWSKGK VRDKLNNLVL FDKATYDKLC KEVPNYKLIT PAVVSERLKI RGSLARAALQ ELLSKGLIKL VSKHRAQVIY TRNTKGGDAP AAGEDA (1-125 aa encoded by B C004986)
靶标信息
Ribosomes, the organelles that catalyze protein synthesis, consist of a small 40S subunit and a large 60S subunit. Together these subunits are composed of 4 RNA species and approximately 80 structurally distinct proteins. This gene encodes a ribosomal protein that is a component of the 40S subunit. The protein belongs to the S25E family of ribosomal proteins. It is located in the cytoplasm.
仅用于科研。不用于诊断过程。未经明确授权不得转售。
生物信息学
蛋白别名: 40S ribosomal protein S25; Small ribosomal subunit protein eS25; unnamed protein product
基因别名: eS25; RPS25; S25
UniProt ID: (Human) P62851
Entrez Gene ID: (Human) 6230